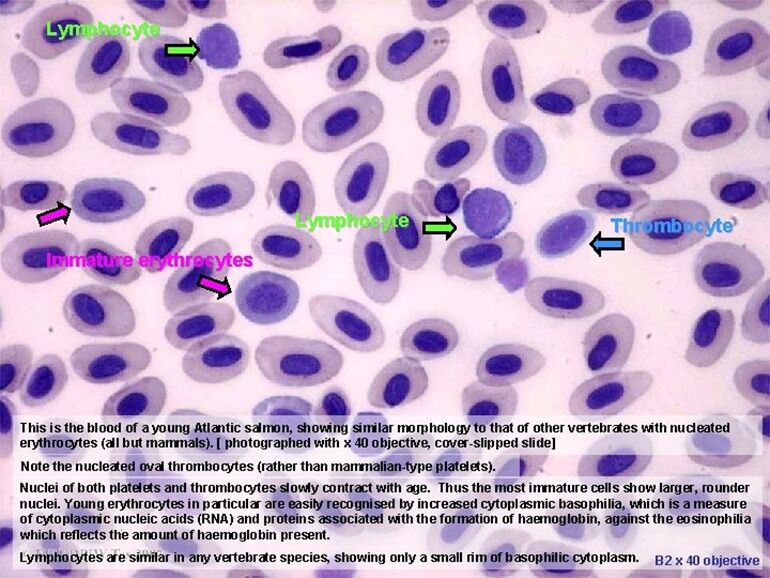
668e37dde0c2c.jpg

22.下圖為何種健康動物之血液抹片?箭頭所指為何種血球?
(A)兔子;monocyte
(B)魚;thrombocyte
(C)雞;monocyte
(D)鴿子;thrombocyte
答案:登入後查看
統計: A(99), B(98), C(1525), D(368), E(0) #2743632
統計: A(99), B(98), C(1525), D(368), E(0) #2743632
詳解 (共 4 筆)
#6159602
(A)兔子血球(圓),其他血球

(B)魚類血球(橢圓有核),其他血球
(C)(D)雞跟鴿子為禽類血球(也是橢圓有核),其他血球

*補充:爬蟲類(蛇、烏龜、蜥蜴)紅血球(橢圓有核),其他血球特殊的有heterophil, azurophil


ㅤㅤ
25
0
#6108367
原文書46頁也有高清圖喔
1
0